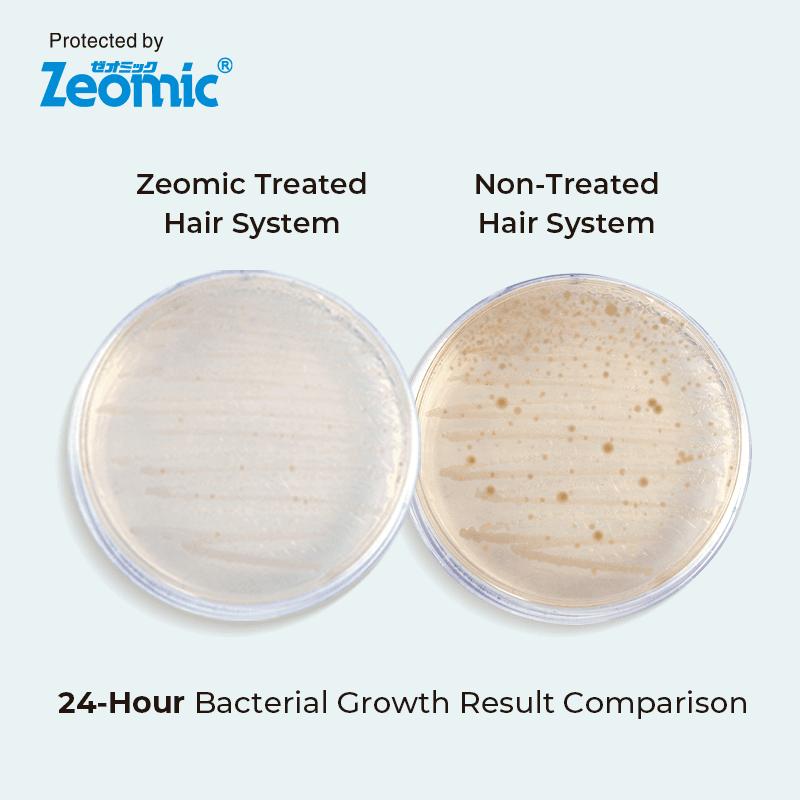

Zeo-Ares | Antimicrobial Hair replacement system
Related Products
Couldn't load pickup availability
Description
Zeo-Ares combines French lace in the front with a 2-inch skin base at the back, complemented by 1/4-inch skin sides for effortless perimeter customization and bonding. The incorporation of skin structure around the cap base facilitates easy application and removal, while enhancing durability with reinforced stitching lines in the lace area and skin structure.
The knots along the front hairline are meticulously bleached for a seamlessly natural appearance.
Additionally, we've incorporated Zeomic additives into the base of Zeo-Ares, elevating standards of hygiene and comfort. Engineered to combat the growth of bacteria, mold, and fungi, these specialized additives ensure a consistently healthy and sanitary wearing experience. Experience the pinnacle of durability, hygiene, and natural aesthetics with Zeo-Ares – your ultimate hair system solution.
Product Specifications
Shipping & Returns
Shipping
- US Ground 5-7 Business days $14.99 (Free with your purchase over $179)
- International 7-10 Business days $29.89 (Free with your purchase over $249)
*Please note that international shipping cannot be upgraded.
*Business days refer to Monday to Friday
Wholesale Accounts
The shipping charge for bulk wholesale orders is $30 for 1 piece, plus $3 for each additional.
Returns
Returns and exchanges are accepted within 45 days from the delivery date. We offer three return options for you to choose from.
*conditions applied
If you have any questions or concerns, please contact us anytime.
See our Shipping Policy & Return Policy for more details.